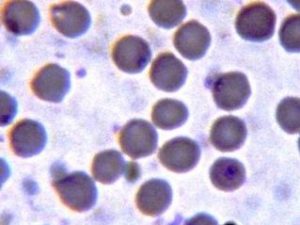
Babesia motasi

Babesia motasi、(赤血球には単一ないし対をなす洋なし状の虫体(2.5~4.0 x 2.0㎛)がみられ、B.bi-geminaに似た大形のバベシア原虫です。
めん羊と山羊に感染性のある株と、めん羊だけに感染するものとがあります。
病原性は強い。
ヨーロッパ、中東、ロシア、東南アジア、アフリカなどに広く分布します。
媒介ダニは、Haemaphysalis属のダニです。
≪めん羊・山羊≫Babesia motasi ~ めん羊と山羊に感染性のある株と、めん羊だけに感染するものとがある
胞子虫類
胞子虫類
